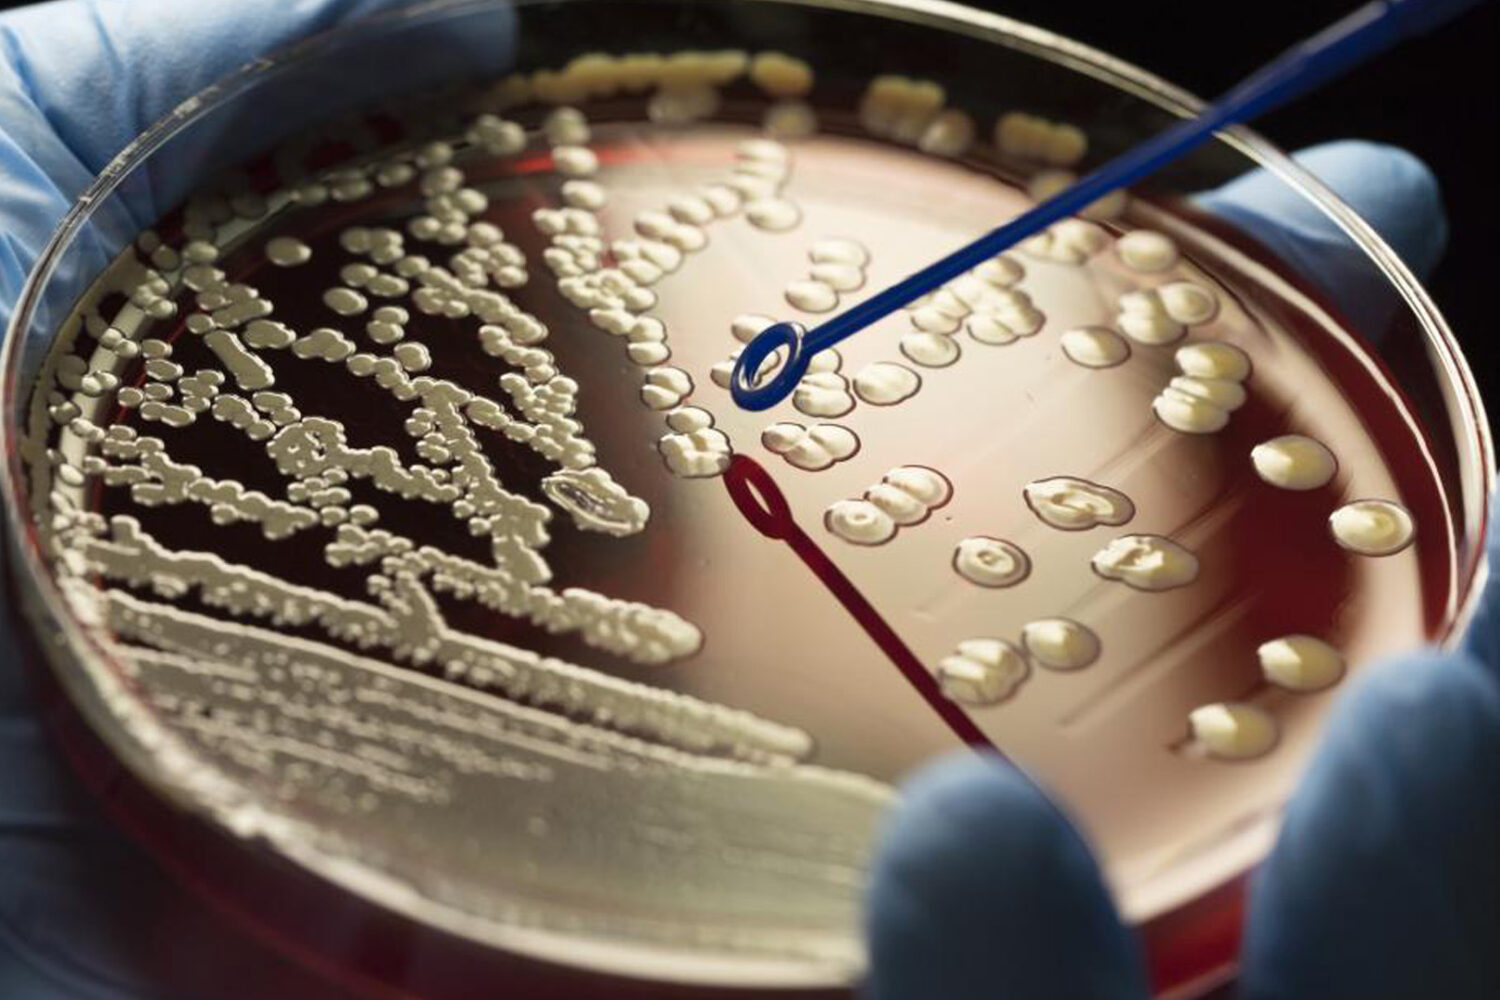
AMR image 1

G20&G7 Health and Development Partnership (G20&G7 HDP) organized the 8th edition of the Health 20 Summit (H20), bringing together policymakers, key players in the global health policy community, and representatives from the private and public sectors to discuss pressing global health and finance issues and support the G20 and G7 convergence of agendas for a sustainable and future-proof policy-making effort.
The attendees drafted a Call to Action based on the discussion held during the two days of the summit, with the goal of fostering a wider and more integrated dialogue with key takeaways from across many sectors of society. This call to action & its recommendations on health, finance, and climate have been sent to the G20 & G7 nations to keep health as a priority at the highest levels of policymaking to ensure our common goals are met in the long-term and aligned with the UN SDG 2030 commitments.
Read the Call To Action here